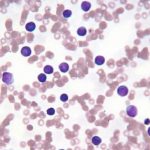
Tình cờ phát hiện loại protein tiêu diệt tế bào ung thư

Phương pháp sinh thiết lỏng giúp phát hiện ung thư
Phương pháp sinh thiết lỏng có khả năng phát hiện các tế bào ung thư di căn tới các bộ phận khác, từ đó có thể phát hiện ung thư và đưa ra những phương pháp điều trị kịp thời.
Hiện nay, bệnh ung thư hoàn toàn có thể được phát hiện sớm thông qua cách thức tìm kiếm các tế bào ung thư lưu hành trong máu hoặc ADN được lấy từ các khối u. Thử nghiệm này sẽ mang lại nhiều hy vọng mới về hướng điều trị đối với các bệnh ung thư.

Các thử nghiệm lâm sàng đang được tiến hành dưới sự bảo trợ của Viện Curie ở Paris, Pháp. Thử nghiệm này được thực hiện với mục đích xác định mối quan hệ giữa tế bào ung thư lưu hành với phương pháp điều trị, xem xét liệu các tế bào này có thể giúp lựa chọn được phương pháp điều trị ung thư ít tác dụng phụ hơn không (bao gồm cả liệu pháp hormone và hóa trị). Tiếp đó, các nhà khoa học sẽ xác định tác động của sự quyết định này trên bệnh nhân và cuối cùng là đánh giá tiện ích lâm sàng của phương pháp trong bối cảnh thực tế, giúp phát hiện ung thư nhanh chóng, theo giáo sư Jean-Yves Pierga, trưởng khoa ung thư của Viện Curie.

Xét nghiệm các mẫu máu có thể giúp phát hiện ung thư và định hướng phương pháp điều trị
Tuy nhiên, khó khăn mà các chuyên gia phải đối mặt chính là làm sao để có thể xác định được các tế bào khối u lưu hành trong máu và ADN từ một mẫu máu đơn giản mà không cần sử dụng phương pháp sinh thiết - lấy một mảnh mô hoặc một mẫu tế bào từ cơ thể để phân tích.

Một thử nghiệm khác của các nhà nghiên cứu Pháp được thực hiện đối với trường hợp ung thư vú. Thử nghiệm nhằm xác định xem các tế bào ung thư lưu hành có mang thụ thể HER2 hay không khi nó không xuất hiện trong khối u nguyên phát. Nếu các nhà nghiên cứu nhận thấy sự xuất hiện của các tế bào ung thư (được xác định tới 8% trong các trường hợp) sẽ giúp họ định hướng được một phương pháp điều trị ung thư nhờ kháng thể HER2 liên quan đến ung thư.

Trước đó, phương pháp sinh thiết lỏng đã được nhóm các nhà nghiên cứu từ Viện Ung thư Vall d’Hebrhon ở Barcelona (Tây Ban Nha) phát hiện ra. Phương pháp sinh thiết lỏng có nhiệm vụ phát hiện khối u não từ dịch não tủy (là chất nhiên liệu, cung cấp các chất dinh dưỡng và lấy đi các chất thải sinh ra trong quá trình chuyển hóa của hệ thống thần kinh trung ương).

Kết quả nghiên cứu đã giúp cho các bác sĩ có thể xác định được trạng thái của các khối u não chỉ cần thủ thuật chọc dò tủy sống đơn giản thay vì thực hiện sinh thiết xâm lấn ở mô não. Nghiên cứu gây chú ý với việc mở ra một cuộc cách mạng mới trong việc phát hiện ung thư.
Theo Thể thao Việt Nam

Tin mới nhất
- Cần mua nấm lim xanh ở đâu Hải Dương và nấm lim xanh rừng là gì?
- Tác dụng lá xạ đen chữa bệnh gan. Cách sử dụng xạ đen hiệu quả
- Cách sử dụng cây xạ đen sắc nước uống và ngâm rượu điều trị bệnh
- Nguyên nhân gây bệnh ung thư khí quản
- Nấm lim xanh bán ở đâu Vĩnh Phúc và giá mua nấm cây lim xanh rừng
- Sốt xuất huyết ở trẻ em – Đề phòng các biến chứng khó lường
- Bác sĩ giải đáp có thể chẩn đoán ung thư thực quản sớm được hay không
- Nấm lim xanh chữa bệnh gì từ công dụng nấm lim xanh Quảng Nam
- Cần bán nấm lim xanh ở Hà Giang và hình ảnh nấm lim xanh tự nhiên
- Chẩn đoán bệnh ung thư túi mật bằng cách nào?
Video
-
 Chuyện lạ
Chú chim cánh cụt bỗng nổi tiếng vì “phải lòng” nhân vật hoạt hình
Chuyện lạ
Chú chim cánh cụt bỗng nổi tiếng vì “phải lòng” nhân vật hoạt hình
-
 Uống nấm lim xanh
Nấm lim xanh ngâm rượu có tác dụng gì cách dùng nấm lim ngâm rượu
Uống nấm lim xanh
Nấm lim xanh ngâm rượu có tác dụng gì cách dùng nấm lim ngâm rượu
- Đại lý nấm lim xanh Bán nấm lim ở Tiền Giang giá và tác dụng nấm lim xanh chữa bệnh gì
-
 Ung thư vòm họng
Sữa có giúp miễn dịch ung thư vòm họng không?
Ung thư vòm họng
Sữa có giúp miễn dịch ung thư vòm họng không?

Tin Liên quan